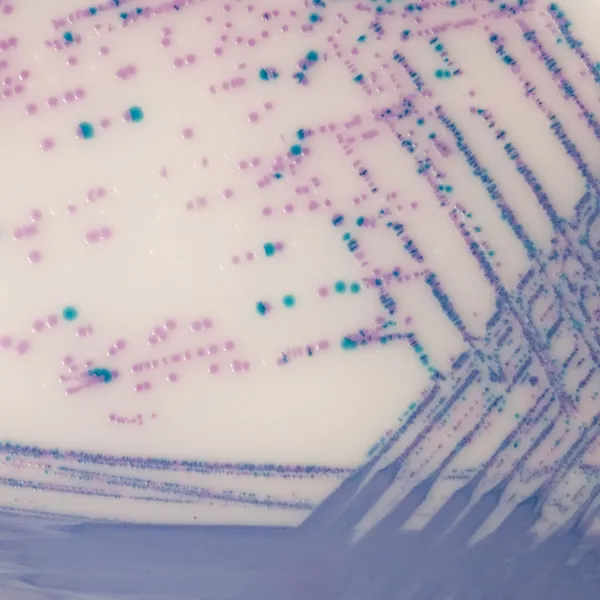
CHROMagar™ Salmonella Plus
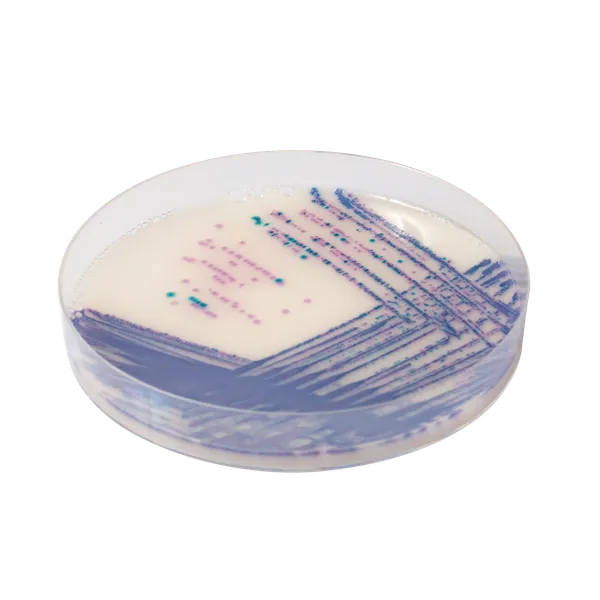
CHROMagar™ Salmonella Plus

Hình thái khuẩn lạc

Salmonella bao gồm S. typhi,
S. paratyphi A và Salmonella dương tính với lactose

Coliforms
xanh dương

E. coli
không màu
Hiệu năng
Hiệu năng
Chủ yếu do sự nhiễm bẩn trong chuỗi thực phẩm và/hoặc trong quá trình sản xuất thực phẩm, Salmonella thường gây ra bệnh lý ruột, các triệu chứng chính bao gồm đau quặn bụng, tiêu chảy, buồn nôn, và nôn mửa.
1. Đáp ứng yêu cầu ISO 6579-1 bằng cách phát hiện Salmonella dương tính với lactose có màu tím nhạt mạnh.
2. Dễ đọc bằng mắt thường: Một đặc điểm khác của môi trường này là sự tương phản màu sắc đẹp mắt nhờ vào E. coli không màu. E. coli, thường tồn tại nhiều trong mẫu thử nghiệm cho Salmonella và có thể che giấu các khuẩn lạc nghi ngờ, không còn là mối lo ngại.
Salmonella bao gồm cả Salmonella dương tính với lactose : 99 %*
*Độ đặc hiệu và độ nhạy từ nghiên cứu khoa học "Đánh giá môi trường chromogen mới CHROMagar™ Salmonella Plus cho phát hiện các loài Salmonella bao gồm Salmonella dương tính với lactose, S. typhi và S. paratyphi" de Beaumont C., Breuil J., Dedicova D., Tran Q. 2006.
Thành phần

Tài liệu kỹ thuật
Công bố khoa học
2024
Diagnostic challenge of gastrointestinal infection due to lactose-fermenting Salmonella enterica subsp. Enterica serovar 4,5:I:-
📄 Publication2023
Viability Real-Time PCR as a Culture-Independent Diagnostic Tool in a Clinical Setting: A Pilot Study to Detect the Viability of Salmonella spp. in Stools
📄 Publication2022
Diagnostic challenge of gastrointestinal infection due to lactose-fermenting Salmonella enterica subsp. enterica serovar 4,5:I:-
📄 Publication2018
Chromogenic media for the detection of Salmonella enterica serovar Paratyphi A in human stool samples: evaluation in a reference setting
📄 Publication2019
Detection of Salmonella serotypes adapted to diverse stresses in poultry meat at the processing level in Portugal
📄 Publication2018
Persistent Infection and Long-Term Carriage of Typhoidal and Nontyphoidal Salmonellae
📄 Publication2016
MICROGEN Salmonella Latex and CHROMagar Salmonella Plus – Comparison Reference Cultures
📄 Publication2014
Development of a novel cross-streaking method for isolation, confirmation, and enumeration of Salmonella from irrigation ponds
📄 Publication2013
Rapid identification of Aeromonas species in stool samples with chromogenic media and matrix-assisted laser desorption ionization-time of flight mass spectrometry: an institutional experience
📄 Publication2006
Evaluation of a new chromogenic medium, CHROMagar™ Salmonella Plus, for the detection of Salmonella spp. including lactose positive Salmonella, S.Typhi and S.Paratyphi
📄 Publication

Xem thêm